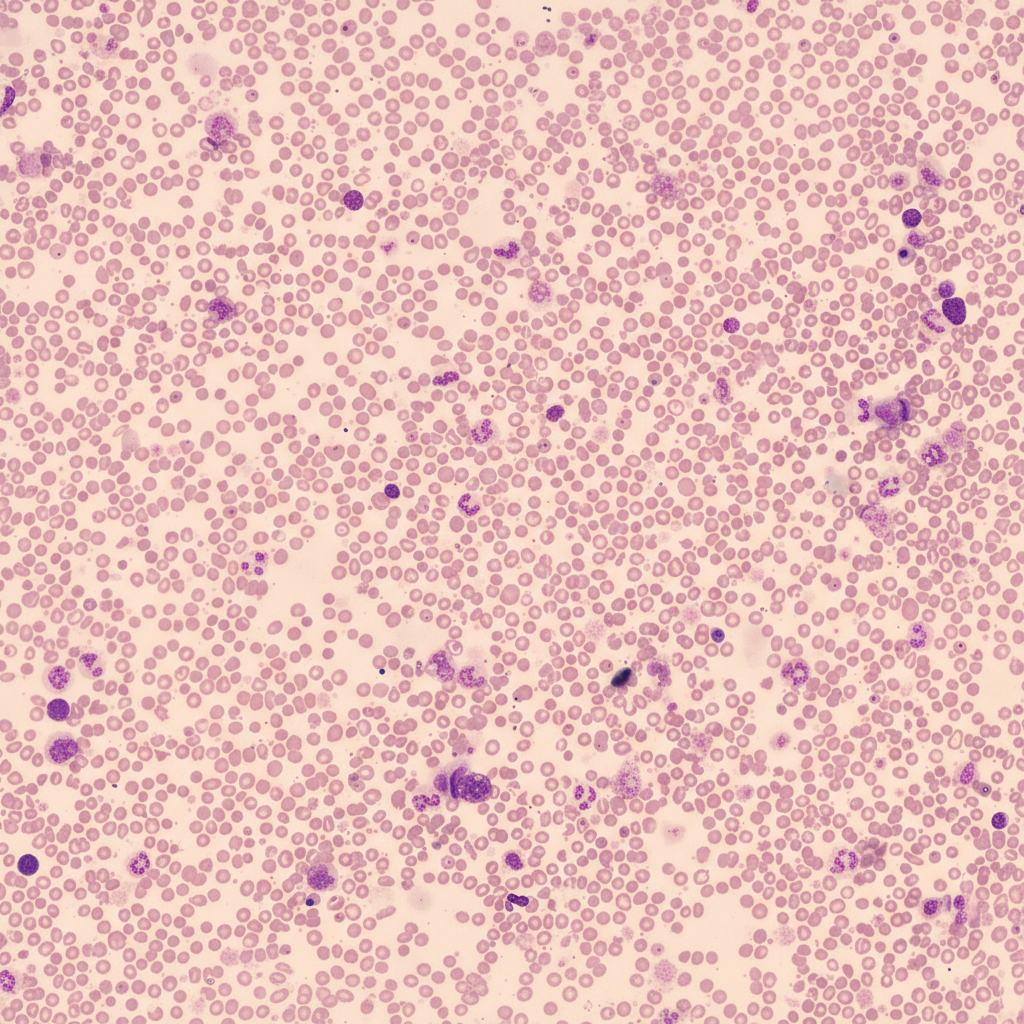
Image for question 272

Enter your email to get your 85% OFF code and unlock the full USMLE question bank on the app.
A 62-year-old woman is seen in the hospital for neutropenic fever. She was admitted 1 week ago for newly diagnosed acute myeloid leukemia. Due to her chemotherapy, she became pancytopenic. Last night, during a packed red blood cell transfusion, she became febrile to 102.6°F (39.3°C), her blood pressure was 92/55, pulse was 112/min, respirations were 16/min, and oxygen saturation was 94% on room air. The transfusion was stopped, intravenous fluids were started, and blood cultures were drawn. The patient also complained of chest pain and shortness of breath. A chest radiograph was obtained and was normal. This morning, she reports "dark urine" but denies dysuria or abnormal vaginal discharge. Her prophylactic antimicrobials started at the time of her chemotherapy include acyclovir, levofloxacin, and fluconazole. The patient's temperature this morning is 98.7°F (37.1°C), blood pressure is 110/72 mmHg, pulse is 88/min, and respirations are 17/min with an oxygen saturation of 95% on room air. On physical examination, she has 1+ pitting peripheral edema of bilateral lower extremities to the mid-shin. Her jugular venous pressure is 6 cm. Her labs show neutropenia, normocytic anemia, thrombocytopenia, elevated lactate dehydrogenase, elevated total bilirubin, and decreased haptoglobin. Coagulation studies show an increase in bleeding time with normal D-dimer levels. Which of the following is the most likely cause of the patient's symptoms?
A 51-year-old man presents to his primary care physician with 3 months of increasing fatigue. He says that he has been feeling short of breath while walking to his office from the parking lot and is no longer able to participate in recreational activities that he enjoys such as hiking. His wife also comments that he has been looking very pale even though they spend a lot of time outdoors. His past medical history is significant for acute kidney injury after losing blood during a car accident as well as alcoholic hepatitis. Physical exam reveals conjunctival pallor, and a peripheral blood smear is obtained with the finding demonstrate in figure A. Which of the following is associated with the most likely cause of this patient's symptoms?
A 70-year-old woman comes to the physician because of a 4-month history of fatigue, worsening swelling of her ankles, and a 5-kg (11-lb) weight gain. Neurologic examination shows diminished two-point discrimination in her fingers. Laboratory studies show a hemoglobin A1c concentration of 9.2% and a creatinine concentration of 1.3 mg/dL. Urine dipstick shows heavy proteinuria. A biopsy specimen of this patient's kidney is most likely to show which of the following?
A 21-year-old woman comes to the physician because of a 1-week history of shortness of breath and dry cough. Eight weeks ago, she received a lung transplant from an unrelated donor. Current medications include prednisone, cyclosporine, and azathioprine. Her temperature is 37.8°C (100.1°F). Physical examination is unremarkable other than a well-healed surgical scar. Pulmonary function tests show a decline in FEV1 and FVC compared to values from several weeks ago. Histological examination of a lung biopsy specimen shows perivascular and interstitial lymphocytic infiltrates with bronchiolar inflammation. This patient's condition is most likely caused by T cell sensitization against which of the following?
A 68-year-old man with alcohol use disorder is brought to the physician by his sister for frequent falls and an unsteady gait over the past 2 months. He has not seen a physician in 10 years. He appears emaciated and inattentive. He is oriented to person only. Physical examination shows a wide-based gait with slow, short steps. Eye examination shows lateral gaze paralysis and horizontal nystagmus. One month later, he dies. Which of the following is the most likely finding on autopsy?
A 57-year-old male with diabetes mellitus type II presents for a routine check-up. His blood glucose levels have been inconsistently controlled with medications and diet since his diagnosis 3 years ago. At this current visit, urinalysis demonstrates albumin levels of 250 mg/day. All prior urinalyses have shown albumin levels below 20 mg/day. At this point in the progression of the patient’s disease, which of the following is the most likely finding seen on kidney biopsy?
A 44-year-old man presents to his primary care physician for muscle pain and weakness. He says that his muscle pain mainly affects his legs. He also experiences difficulty with chewing gum and has poor finger dexterity. Medical history is significant for infertility and cataracts. On physical exam, the patient's face is long and narrow with a high arched palate and mild frontal balding. There is bilateral ptosis and temporalis muscle and sternocleidomastoid muscle wasting. Creatine kinase level is mildly elevated. Which of the following is most likely to be found on genetic testing?
A 31-year-old woman presents to the emergency department with a 2-week history of dry cough and shortness of breath on exertion. She says that she has also been feeling joint pain that has been increasing over time and is worst in the mornings. Finally, she has noticed painful swellings that have been appearing on her body over the last month. Her past medical history is significant for childhood asthma that does not require any current medications. She drinks socially and has smoked 2 packs per day since she was 16 years old. Physical exam reveals erythematous nodular lesions on her trunk and upper extremities. Serum protein electrophoresis shows polyclonal gammopathy. Which of the following would most likely also be seen in this patient?
A 33-year-old woman comes to the physician for the evaluation of bleeding from her gums for 2 weeks. These episodes occur spontaneously and are self-limiting. She has also had purplish skin lesions over her legs for 2 months. Last week, she had one episode of hematuria and watery diarrhea, both of which resolved without treatment. She has mild asthma. Her brother has hemophilia. Her only medication is a fenoterol inhaler. She appears healthy. Her temperature is 37.1°C (99.3°F), pulse is 88/min, respirations are 14/min, and blood pressure is 122/74 mm Hg. Cardiopulmonary examination shows no abnormalities. The abdomen is soft and nontender; there is no organomegaly. Oropharyngeal examination shows gingival bleeding. There are petechiae over the neck and the right upper extremity and purpuric spots over both lower extremities. Laboratory studies show: Hemoglobin 13.3 mg/dL Mean corpuscular volume 94 μm3 Leukocyte count 8,800/mm3 Platelet count 18,000/mm3 Bleeding time 9 minutes Prothrombin time 14 seconds (INR=0.9) Partial thromboplastin time 35 seconds Serum Glucose 88 mg/dL Creatinine 0.9 mg/dL Which of the following is the most likely underlying mechanism of this patient's symptoms?
A 48-year-old African American male presents to his primary care provider complaining of facial swelling. He reports a three-day history of worsening swelling primarily around his eyes. The patient’s medical history is notable for sickle cell disease and poorly controlled hypertension. The patient currently takes enalapril, hydrochlorothiazide, and amlodipine but has a history of medication non-adherence. He has a 15 pack-year smoking history. His temperature is 99.1°F (37.3°C), blood pressure is 155/100 mmHg, pulse is 90/min, and respirations are 20/min. Physical examination is notable for periorbital swelling and 1+ bilateral lower extremity edema. Multiple serum and urine labs are ordered. A kidney biopsy in this patient would most likely yield which of the following sets of findings on light and electron microscopy?
Liver pathology (hepatitis, cirrhosis)
Practice Questions
Gallbladder and biliary tract disorders
Practice Questions
Pancreatic diseases
Practice Questions
Kidney diseases
Practice Questions
Male reproductive pathology
Practice Questions
Female reproductive pathology
Practice Questions
Breast pathology
Practice Questions
Endocrine pathology
Practice Questions
Bone and joint pathology
Practice Questions
Skeletal muscle diseases
Practice Questions
Peripheral nerve disorders
Practice Questions
Soft tissue tumors
Practice Questions
Head and neck pathology
Practice Questions
Get full access to all questions, explanations, and performance tracking.
Scan to download app